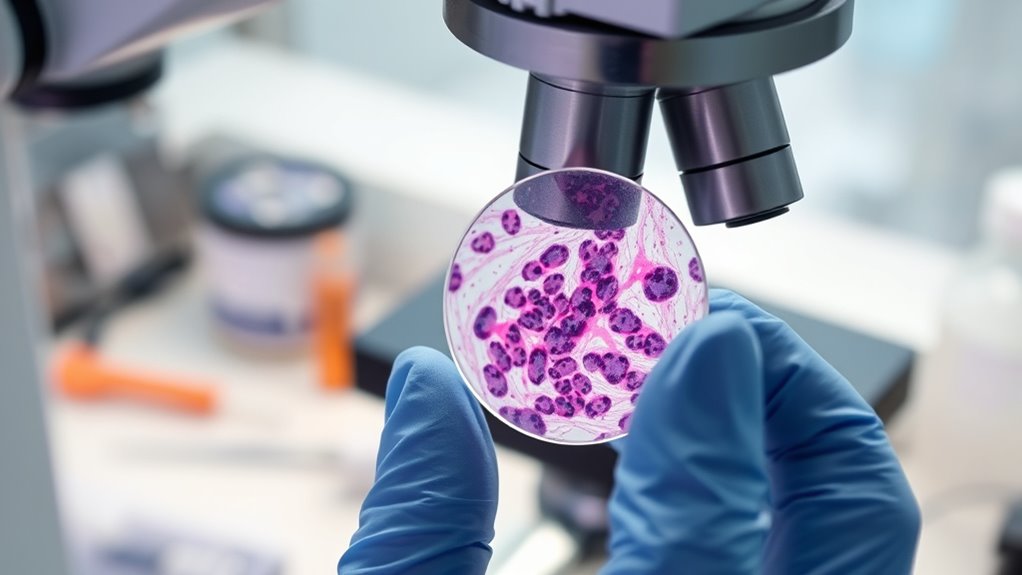
Erkennung von Resistenz und neuen Zielstrukturen

Wenn man Metastasen biopsiert, bestätigt man, ob sie tatsächlich bösartig sind, und unterscheidet sie von gutartigen Erkrankungen. Dies trägt dazu bei, eine genaue Diagnose, Stadieneinteilung und personalisierte Behandlungspläne zu gewährleisten. Es zeigt auch, ob es sich um einen zweiten Primärtumor handelt, was unnötige oder unangemessene Therapien verhindern kann. Darüber hinaus offenbart die Untersuchung des Gewebes Veränderungen in Rezeptor- oder Molekularprofilen, die gezielte Therapien leiten und Resistenz erkennen. Die Fortsetzung wird weitere Gründe aufdecken, warum die histologische Analyse von Metastasen für eine optimale Krebsbehandlung unerlässlich ist.
Wichtige Erkenntnisse
- Bestätigung der metastatischen Natur der Läsion und Unterscheidung von benignen Zuständen oder anderen Primärtumoren.
- Erkennung sekundärer Primärtumoren, um eine genaue Diagnose und eine angemessene Behandlung sicherzustellen.
- Beurteilung von Rezeptor- und molekularen Profiländerungen für eine personalisierte Therapieanpassung.
- Verbesserung der Staging-Genauigkeit und Unterstützung bei der effektiven Behandlungsplanung.
- Verhinderung unnötiger Behandlungen durch die präzise Unterscheidung zwischen benignen und malignen Läsionen.
Bestätigung der Malignität durch Gewebeanalyse

Um Malignität zu bestätigen, liefert eine Biopsie von metastatischen Läsionen direkte mikroskopische Nachweise von Krebszellen, die eine endgültige Diagnose über klinischen Verdacht und Bildgebungsbefunde hinaus ermöglichen. Bei einer Biopsie entnehmen Sie Gewebeproben, die Pathologen unter dem Mikroskop untersuchen, um bösartige Zellen zu identifizieren. Dieser Prozess hilft, wahre Metastasen von gutartigen Läsionen oder entzündlichen Zuständen zu unterscheiden, die Krebs imitieren und in etwa 9,5 % der Fälle auftreten. Die Bestätigung der Malignität *sichert*, dass Sie keine Fehldiagnosen stellen oder unnötige Behandlungen durchführen, und unterstützt die genaue Stadieneinteilung Ihres Krebses. Eine präzise Gewebe-Diagnose lenkt die angemessene Behandlungsplanung, vermeidet unnötige Therapien und verbessert die Prognosebewertung, indem das Vorhandensein und das Ausmaß der Metastasen bestätigt werden. Dadurch ist die Biopsie ein wesentlicher Schritt bei der effektiven Behandlung von metastatischer Erkrankung. Zusätzlich verbessern die spezialisierten Techniken in der modernen Pathologie die Genauigkeit bei der Diagnose metastatischer Gewebeproben.
Unterscheidung von Metastasen und benignen Läsionen

Während die Bestätigung der Malignität durch Gewebeanalysen unerlässlich ist, ist es ebenso wichtig, echte Metastasen genau von benignen Läsionen oder entzündlichen Zuständen zu unterscheiden, die Krebs nachahmen können. Benigne Prozesse, wie Granulome, Zysten oder reaktive Gewebeänderungen, können sowohl auf Bildern als auch histologisch ähnlich wie Metastasen erscheinen. Eine Biopsie hilft, diese Unklarheiten zu klären und Fehldiagnosen zu vermeiden. Sie sollten auf spezifische histologische Merkmale achten — wie zelluläre Atypien, Invasionsmuster und Gewebearchitektur — die benigne von malignen Geweben unterscheiden. Immunhistochemische Färbungen unterstützen diese Unterscheidung zusätzlich durch die Identifizierung von Markern, die typisch für maligne Zellen sind. Die korrekte Identifikation benignen Läsionen vermeidet unnötige Behandlungen und invasive Eingriffe, sodass nur echte Metastasen gezielt behandelt werden. Diese Präzision verbessert die diagnostische Genauigkeit, steuert die angemessene Behandlung und verhindert Übertherapien aufgrund falscher Verdachtsmomente.
Bewertung von Veränderungen im Rezeptor- und Molekülprofil

Das Biopsieren von metastatischen Läsionen ermöglicht es, Veränderungen im Rezeptor- und Molekularprofil zu bewerten, die vom Primärtumor abweichen können. Diese Erkenntnisse sind entscheidend, um die Behandlung individuell anzupassen. Sie können:
- Immunhistochemische Tests durchführen, um Rezeptoren wie ER, PR und HER2 zu beurteilen, was potenzielle Veränderungen in der Tumorbiologie aufzeigt.
- Dissoziationsraten erkennen – beispielsweise ER (14,6%), PR (16,7%) und HER2 (8,3%) – die die Therapiewahl beeinflussen.
- Aufkommende Resistenzmechanismen oder neue molekulare Zielstrukturen identifizieren, um wirksamere gezielte Therapien zu ermöglichen.
- Systemische Behandlungen personalisieren, basierend auf dem aktuellen Rezeptorstatus des Tumors, sodass die Therapien mit der Biologie der Metastase statt des Primärtumors übereinstimmen.
Dieser Prozess trägt dazu bei, Behandlungsstrategien zu optimieren und die Patientenergebnisse durch präzise, aktuelle Tumorprofile zu verbessern.
Erkennung eines zweiten Primärtumors

Das Erkennen eines zweiten Primärtumors während einer Metastasenbiopsie ist entscheidend, da es die Diagnose und Behandlungspläne erheblich verändern kann. Das Erkennen dieser neuen Malignitäten stellt sicher, dass sie nicht mit Metastasen verwechselt werden, was zu einer unangemessenen Therapie führen könnte. Ein zweiter Primärtumor erfordert möglicherweise ganz andere Behandlungsstrategien und beeinflusst die Prognose. Zur Veranschaulichung hier einige Beispiele:
| Tumortyp | Häufige Lage | Bedeutung |
|---|---|---|
| Lungenkrebs | Lunge | Unterschiedliches Staging, Behandlung |
| Bauchspeicheldrüsenkrebs | Bauchraum | Neue chirurgische oder chemo-, immuntherapeutische Ansätze |
| Melanom | Haut oder Lymphknoten | Anpassung der zielgerichteten Therapie |
| Hämatologische Malignome | Blut, Knochenmark | Unterschiedliche Behandlungsprotokolle |
Frühe Erkennung ermöglicht eine maßgeschneiderte Intervention, optimiert die Patientenergebnisse und vermeidet Fehlklassifikationen.
Vermeidung unnötiger oder unangemessener Behandlungen

Die Durchführung einer Biopsie von metastatischen Läsionen ist entscheidend, um unnötige oder unangemessene Behandlungen zu vermeiden. Sie bestätigt, ob eine Läsion tatsächlich metastatisch ist, und schützt Sie vor unnötiger systemischer Therapie. Hier ist, wie sie hilft:
Biopsien bestätigen Metastasen, leiten eine genaue Behandlung ein und vermeiden unnötige Therapien.
- Unterscheidung zwischen benignen und malignen Läsionen: Die Biopsie schließt falsch-positive Ergebnisse aus, sodass Sie keine Behandlung für gutartige oder reaktive Läsionen erhalten.
- Aufdeckung histologischer Unterschiede: Sie erkennt, ob es sich um einen anderen Primärtumor handelt, was die richtige Therapie lenkt.
- Erkennung von Rezeptorverschiebungen: Sie zeigt Veränderungen im Hormon- oder HER2-Status, um ineffektive Behandlungen zu vermeiden.
- Vermeidung von Überbehandlung: Die Bestätigung der Metastase verhindert invasive Eingriffe oder Therapien, die keinen Nutzen bringen, was Nebenwirkungen reduziert und die Lebensqualität verbessert.
- Bietet histologische Einblicke: Sie hilft, Krebs-Heterogenität zu verstehen, was die Behandlungsentscheidungen beeinflussen und die Ergebnisse verbessern kann.
Kurz gesagt, sorgt eine Biopsie dafür, dass Ihr Behandlungsplan auf Ihren aktuellen Krankheitszustand abgestimmt, effektiv und angemessen ist.
Leitfaden für personalisierte systemische Therapie

Eine metastatische Biopsie liefert wichtige Informationen, die Ihre systemische Therapiewahl direkt beeinflussen. Durch die Analyse von Gewebeproben können Sie den aktuellen Rezeptorstatus ermitteln—wie ER, PR und HER2—which sich vom ursprünglichen Tumor unterscheiden kann. Dies hilft, gezielte Behandlungen individuell anzupassen und sicherzustellen, dass Sie nicht mit unwirksamen Optionen behandelt werden. Außerdem offenbart die Biopsie molekulare Veränderungen oder Resistenzmechanismen, die sich möglicherweise entwickelt haben, und ermöglicht so Anpassungen in der Therapie. Zusätzlich kann die Biopsie neue molekulare Targets oder Mutationen identifizieren, was Chancen für personalisierte Behandlungen oder klinische Studien eröffnet. Das genaue Verständnis der Eigenschaften Ihrer Metastase erlaubt es Ihrem medizinischen Team, die passendsten hormonellen, zielgerichteten oder chemotherapeutischen Mittel auszuwählen. Dieser präzise Ansatz zielt darauf ab, die Wirksamkeit zu verbessern, unnötige Nebenwirkungen zu minimieren und Ihre Behandlungsergebnisse zu optimieren. Das Verständnis des Verhältnisses des Kontrastverhältnisses in der Bildgebung kann zudem die Tumorerkennung und -bewertung verbessern.
Erkennung von Widerstand und neuen Zielen
Erkennung von Resistenz und neuen Zielstrukturen bei metastatischer Erkrankung ist essenziell, weil Tumoren sich oft unter Behandlungsdruck weiterentwickeln und Mechanismen ausbilden, die die Wirksamkeit der Therapie verringern. Ihre Biopsie kann diese Veränderungen offenbaren und so Anpassungen in Ihrem Behandlungsplan ermöglichen. Hier sind die Punkte, auf die Sie sich konzentrieren sollten:
- Erkennung molekularer Veränderungen, die Resistenz verleihen, wie Mutationen oder Rezeptorverlust.
- Identifizierung neuer molekularer Zielstrukturen, wie aufkommende HER2-Amplifikation oder PIK3CA-Mutationen.
- Überwachung von Veränderungen im Rezeptorstatus, die die Hormon- oder zielgerichtete Therapie beeinflussen können.
- Erkennung genetischer oder epigenetischer Veränderungen, die auf alternative Wachstumswege des Tumors hindeuten.
- Einbeziehung von Erkenntnissen aus Ethical Hacking, um Schwachstellen und Anpassungen zu verstehen, die bei der Entwicklung gezielter Therapiestrategien hilfreich sein können.
Klären unklarer oder ungewöhnlicher Läsionen

Wenn Sie auf zweideutige oder ungewöhnliche Läsionen stoßen, hilft eine Biopsie dabei festzustellen, ob sie gutartig oder bösartig sind. Sie bestätigt die metastatische Natur verdächtiger Läsionen, verhindert Fehldiagnosen und unnötige Behandlungen. Eine genaue Differenzierung leitet die geeignete Behandlung und vermeidet Überbehandlung oder verpasste Diagnosen. Die Integration von persönlichen Wachstums-Strategien wie Achtsamkeit kann auch die emotionale Widerstandsfähigkeit während Diagnose und Behandlung unterstützen.
Unterscheidung zwischen gutartig und bösartig
Unterscheidung zwischen gutartigen und bösartigen Läsionen stellt oft eine diagnostische Herausforderung dar, insbesondere wenn Bildgebung oder klinische Merkmale uneindeutig oder atypisch sind. In solchen Fällen müssen Sie sich auf histologische Untersuchungen verlassen, um Klarheit zu schaffen. Hier sind wichtige Punkte, die Sie bedenken sollten:
- Biopsie liefert direkte Gewebeprobenanalyse, wodurch Sie zelluläre Merkmale erkennen können, die auf Malignität oder Benigne hinweisen.
- Sie hilft dabei, entzündliche oder reaktive Läsionen auszuschließen, die Krebs vortäuschen, um unnötige Behandlungen zu vermeiden.
- Die Histologie zeigt Tumorgrad, Differenzierung und Mitoserate, was die Prognose und die Behandlung lenkt.
- Die mikroskopische Auswertung erkennt potenzielle zweite Primärtumore, die ähnlich erscheinen, aber unterschiedliche Therapien erfordern.
Bestätigung der metastatischen Natur
Klärung, ob eine Läsion tatsächlich metastatisch ist, kann schwierig sein, wenn klinische und bildgebende Befunde unklar oder atypisch sind. Sie benötigen eindeutigen Nachweis, um Fehldiagnosen und unangemessene Behandlungen zu vermeiden. Eine Biopsie liefert diese Bestätigung, indem sie eine mikroskopische Untersuchung des Gewebes ermöglicht. Sie hilft, Metastasen von benignen oder entzündlichen Zuständen zu unterscheiden, die Krebs nachahmen können. Die Bestätigung der metastatischen Natur ist entscheidend für eine genaue Stadieneinteilung und Prognose. Berücksichtigen Sie die folgende emotionale Auswirkung:
| Situation | Ihre Handlung | Ergebnis |
|---|---|---|
| Unsicherer Befund des Läsionsbildes | Gezielte Biopsie durchführen | Klare Diagnose, Seelenfrieden |
| Atypische Bildgebungsergebnisse | Gewebeprobe entnehmen | Vermeidung unnötiger Behandlungen |
| Verdächtig, aber unklar | Metastase histologisch bestätigen | Angemessene, maßgeschneiderte Therapie |
| Potenziell benigne Läsionen | Metastase ausschließen | Überbehandlung verhindern |
Dieser Prozess stellt sicher, dass Ihre Behandlung mit der wahren Natur der Läsion übereinstimmt.
Verbesserung der Genauigkeit bei der Stadieneinteilung und Behandlung von Krebs

Durch das Durchführen von Biopsien an metastatischen Läsionen gewinnen Sie wichtige Informationen, die die Krebsstadieneinschätzung verbessern und Behandlungsentscheidungen leiten. Diese Gewebeproben bestätigen die Anwesenheit von Malignität, zeigen Änderungen im Rezeptorstatus auf und erkennen Zweitmalignome, sodass Ihre Behandlungsstrategien genau sind. Dieser gezielte Ansatz hilft Ihnen, Therapien zu personalisieren und unnötige Behandlungen zu vermeiden, was letztlich zu besseren Patientenergebnissen führt.
Präzise Krankheitscharakterisierung
Genaues Krankheitsverständnis ist entscheidend für die präzise Stadieneinteilung und effektive Behandlung von Krebs. Es stellt sicher, dass Sie die wahre Natur der Metastase erfassen und geeignete Therapieentscheidungen treffen können. So verbessert eine Biopsie diesen Prozess:
- Bestätigung der Malignität durch mikroskopische Gewebeuntersuchung, um gutartige oder entzündliche Mimics auszuschließen.
- Identifikation von Rezeptorstatus und molekularen Veränderungen, die Diskrepanzen zum Primärtumor aufdecken und gezielte Therapien informieren.
- Erkennung von zweiten Primärtumoren, um Fehlklassifikationen zu vermeiden und die Behandlungspläne entsprechend anzupassen.
- Ausschluss von Falsch-Positiven, insbesondere bei verdächtigen Läsionen, die möglicherweise gutartig sind, um unnötige Behandlungen zu vermeiden.
Diese Schritte verfeinern die Diagnose, optimieren die Therapiewahl und verbessern die Patientenergebnisse, indem sie ein klares, genaues Bild des Krankheitsstatus liefern. Biopsien sind unerlässlich für eine präzise, informierte Behandlung des metastatischen Krebses.
Personalisierte Behandlungsplanung
Personalisierte Behandlungsplanung nutzt Biopsieergebnisse, um Therapien speziell auf das aktuelle Tumorprofil jedes Patienten zuzuschneiden. Durch die Analyse metastatischer Gewebe gewinnen Sie detaillierte Einblicke in den Rezeptorstatus, molekulare Veränderungen und potenzielle Resistenzmechanismen. Diese Informationen ermöglichen es Ihnen, systemische Behandlungen wie Hormontherapie, zielgerichtete Wirkstoffe oder Chemotherapie basierend auf den neuesten Tumoreigenschaften anzupassen. Außerdem helfen sie, neue molekulare Zielstrukturen oder aufkommende Resistenz zu identifizieren, um Ihre Herangehensweise stets wirksam zu halten. Zusätzlich kann die Biopsie sekundäre Primärtumoren aufdecken, was zu unterschiedlichen Behandlungsstrategien führt. Eine präzise histologische Bestätigung verhindert unnötige Behandlungen gutartiger Erkrankungen. Insgesamt verbessert die Integration von Biopsiedaten in Ihre Planung die Präzision, optimiert die Ergebnisse und unterstützt fundierte Entscheidungen bezüglich Operation, Strahlentherapie oder der Eignung für klinische Studien, wodurch die Krebsbehandlung Ihrer Patienten individuell gestaltet wird.
Häufig gestellte Fragen
Wie zuverlässig ist eine Biopsie im Vergleich zu bildgebenden Verfahren allein bei der Diagnose von Metastasen?
Biopsien sind weitaus zuverlässiger als Bildgebung allein bei der Diagnose von Metastasen. Während die Bildgebung dabei hilft, verdächtige Läsionen zu identifizieren, kann sie nicht endgültig zwischen gutartigen und bösartigen Veränderungen unterscheiden oder Metastasen histologisch bestätigen. Eine Biopsie liefert eine direkte Gewebeuntersuchung, bestätigt die Malignität, den Rezeptorstatus und schließt falsch positive Ergebnisse oder gutartige Zustände aus. Diese Genauigkeit garantiert die richtige Stadieneinteilung, Therapieentscheidungen und vermeidet unnötige Behandlungen, was sie für eine präzise Diagnose unerlässlich macht, über das hinaus, was die Bildgebung bieten kann.
Welche Risiken oder Komplikationen sind mit Biopsien von metastatischen Läsionen verbunden?
Sie könnten sich Sorgen über Risiken bei Biopsien von metastatischen Läsionen machen, aber sie sind im Allgemeinen sicher. Zu den häufigen Komplikationen gehören Blutungen, Infektionen oder Schmerzen an der Biopsiestelle. Selten besteht die Möglichkeit von Schäden an umliegenden Geweben oder Nerven. Die Verwendung bildgebender Verfahren zur Führung minimiert diese Risiken, und sorgfältige Planung gewährleistet die Sicherheit. Obwohl Komplikationen selten sind, hilft es, darüber Bescheid zu wissen, um informierte Entscheidungen treffen zu können und sich auf notwendige Nachsorge oder Behandlung vorzubereiten.
Kann eine Biopsie alle relevanten molekularen Marker für die zielgerichtete Therapie erkennen?
Biopsien können viele wichtige molekulare Marker wie ER, PR und HER2 identifizieren, die gezielte Therapien leiten. Allerdings erkennen sie möglicherweise nicht alle relevanten Mutationen oder genetischen Veränderungen, insbesondere jene, die nur in kleinen Tumor-Unterklonen vorhanden sind. Tumorheterogenität kann die Marker-Erkennung einschränken, sodass manchmal zusätzliche Tests wie liquid Biopsien oder fortgeschrittene molekulare Analysen notwendig sind, um personalisierte Behandlungspläne vollständig zu informieren.
Wie häufig ändern Metastasen den Rezeptorstatus im Vergleich zu Primärtumoren?
Metastasen verändern den Rezeptorstatus im Vergleich zu den Primärtumoren bei etwa 14,6 % für ER, 16,7 % für PR und 8,3 % für HER2. Es wird empfohlen, bioptische Untersuchungen an metastatischen Läsionen durchzuführen, da diese Veränderungen die Behandlungsentscheidungen erheblich beeinflussen können. Der Rezeptorstatus kann sich durch Tumorprogression oder Therapieresistenz weiterentwickeln. Eine Bestätigung der aktuellen Profile stellt sicher, dass Sie die effektivsten zielgerichteten Therapien auswählen und unwirksame Behandlungen vermeiden, die auf veralteten Informationen basieren.
Ist eine Biopsie bei allen vermuteten metastatischen Läsionen erforderlich oder nur in bestimmten Fällen?
Denken Sie an Biopsie als den Detektiv Ihres Tumors, der versteckte Geheimnisse unter der Oberfläche aufdeckt. Es ist nicht notwendig, jede verdächtige Läsion zu biopsieren, aber es ist unerlässlich, wenn die Diagnose die Behandlung beeinflusst, ungewöhnliche Merkmale zeigt oder das Risiko für zweite primäre Tumoren besteht. In solchen Fällen wirkt die Biopsie wie ein Wahrheitsserum, das Malignität bestätigt, Rezeptorstatus offenbart oder neue Krebserkrankungen erkennt, um sicherzustellen, dass Sie die genaueste, personalisierte Versorgung erhalten.
Fazit
Selbst wenn Fernmetastasen vorliegen, solltest du die Biopsie nicht überspringen—denke daran als den Fingerabdruck deines Krebses, der wesentliche Wahrheiten offenbart. Sie hilft dir, die Malignität zu bestätigen, verborgene Ziele zu entdecken und Behandlungen präzise zuzuschneiden, wie ein Meisterhandwerker. Indem du auch die kleinste Läsion untersuchst, malst du ein klareres Bild der Krankheitsgeschichte und leitest deine Entscheidungen durch den Nebel hindurch. Denke daran, jede Biopsie ist ein Leuchtturm, der den Weg zu personalisierter, effektiver Krebstherapie erleuchtet.